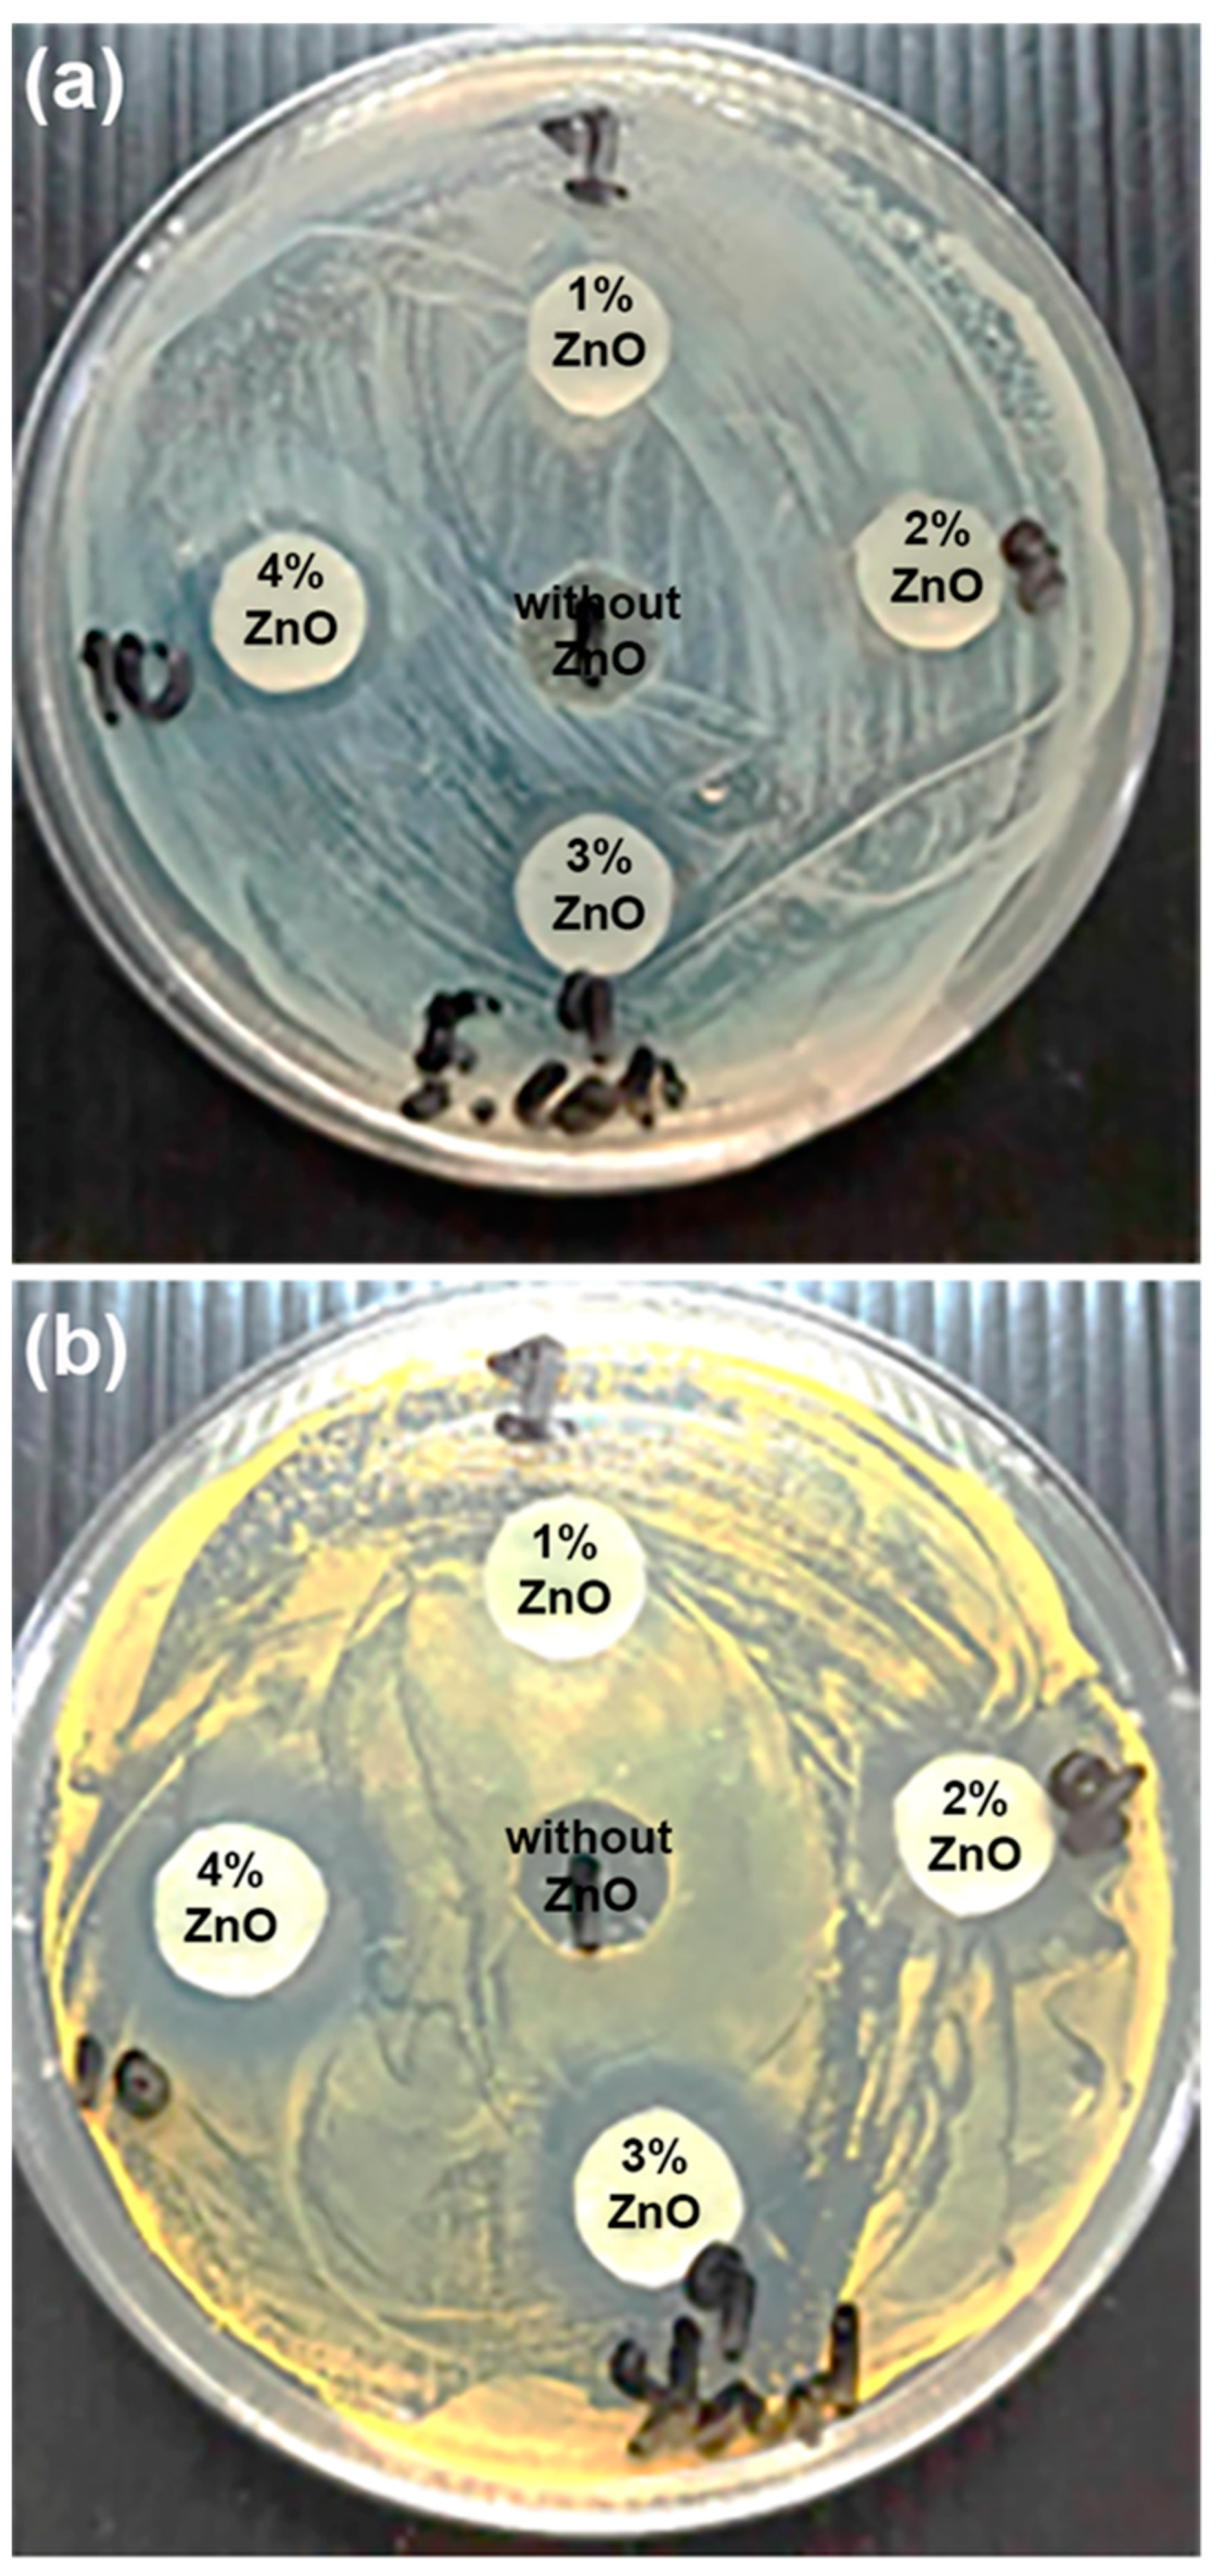
Polymers 16 01660 g013

Preparation of Poly(L-lactide)-b-poly(ethylene glycol)-b-poly(L-lactide)/Zinc Oxide Nanocomposite Bioplastics for Potential Use as Flexible and Antibacterial Food Packaging
Abstract
1. Introduction
2. Materials and Methods
2.1. Materials
2.2. Preparation of PLLA-PEG-PLLA/ZnO Nanocomposites
2.3. Characterization of PLLA-PEG-PLLA/ZnO Nanocomposites
3. Results and Discussion
3.1. Thermal Transition Properties
3.2. Thermal Decomposition Properties
3.3. Phase Morphology
3.4. Crystalline Structures
3.5. Tensile Properties
3.6. Opacity and UV-Barrier Property
3.7. Moisture Uptake
3.8. Antibacterial Properties
4. Conclusions
Author Contributions
Funding
Institutional Review Board Statement
Data Availability Statement
Conflicts of Interest
References
- Kamarudin, S.H.; Rayung, M.; Abu, F.; Ahmad, S.; Fadil, F.; Karim, A.A.; Norizan, M.N.; Sarifuddin, N.; Mat Desa, M.S.Z.; Mohd Basri, M.S.; et al. A review on antimicrobial packaging from biodegradable polymer composites. Polymers 2022, 14, 174. [Google Scholar] [CrossRef] [PubMed]
- Wang, J.; Euring, M.; Ostendorf, K.; Zhang, K. Biobased materials for food packaging. J. Bioresour. Bioprod. 2022, 7, 1–13. [Google Scholar] [CrossRef]
- Rodrigues, P.V.; Cunha, A.B.; Andrade, M.A.; Vilarinho, F.; Machado, A.V.; Castro, M.C.R. Blown film of PLA for packaging with green tea and fish industrial residues: An insight on their properties. Food Packag. Shelf. 2024, 43, 101283. [Google Scholar] [CrossRef]
- Castro-Aguirre, E.; Iñiguez-Franco, F.; Samsudin, H.; Fang, X.; Auras, R. Poly(lactic acid)—Mass production, processing, industrial applications, and end of life. Adv. Drug Deliv. Rev. 2016, 107, 333–366. [Google Scholar] [CrossRef] [PubMed]
- Yanat, M.; Muthurajan, M.; Strubel, M.; Grolle, K.; Schroen, K. Polylactic acid films reinforced with chitin nanocrystals: Biodegradation and migration behavior. Food Packag. Shelf. 2023, 40, 101217. [Google Scholar] [CrossRef]
- Petrovics, N.; Kirchkeszner, C.; Patkó, A.; Tábi, T.; Magyar, N.; Székely, I.K.; Szabó, B.S.; Nyiri, Z.; Eke, Z. Effect of crystallinity on the migration of plastic additives from polylactic acid-based food contact plastics. Food Packag. Shelf. 2023, 36, 101054. [Google Scholar] [CrossRef]
- Vidal, C.P.; Luzi, F.; Puglia, D.; López-Carballo, G.; Rojas, A.; Galotto, M.J.; de Dicastillo, C.L. Development of a sustainable and antibacterial food packaging material based in a biopolymeric multilayer system composed by polylactic acid, chitosan, cellulose nanocrystals and ethyl lauroyl alginate. Food Packag. Shelf. 2023, 36, 10150. [Google Scholar]
- Rodrigues, P.V.; Vieira, D.M.; Martins, P.C.; Martins, V.G.; Castro, M.C.R.; Machado, A.V. Evaluation of active LDPE films for packaging of fresh orange juice. Polymers 2023, 15, 50. [Google Scholar] [CrossRef] [PubMed]
- Alves, J.; Gaspar, P.D.; Lima, T.M.; Silva, P.D. What is the role of active packaging in the future of food sustainability? A systematic review. J. Sci. Food Agric. 2023, 103, 1004–1020. [Google Scholar] [CrossRef]
- Guarnieri, A.; Triunfo, M.; Scieuzo, C.; Ianniciello, D.; Tafi, E.; Hahn, T.; Zibek, S.; Salvia, R.; Bonis, A.D.; Patrizia Falabella, P. Antimicrobial properties of chitosan from different developmental stages of the bioconverter insect Hermetia illucens. Sci. Rep. 2022, 12, 8084. [Google Scholar] [CrossRef]
- Krepker, M.; Prinz-Setter, O.; Shemesh, R.; Vaxman, A.; Alperstein, D.; Segal, E. Antimicrobial carvacrol-containing polypropylene films: Composition, structure and function. Polymers 2018, 10, 79. [Google Scholar] [CrossRef] [PubMed]
- Sánchez-López, E.; Gomes, D.; Esteruelas, G.; Bonilla, L.; Lopez-Machado, A.L.; Galindo, R.; Cano, A.; Espina, M.; Ettcheto, M.; Camins, A.; et al. Metal-based nanoparticles as antimicrobial agents: An overview. Nanomaterials 2020, 10, 292. [Google Scholar] [CrossRef] [PubMed]
- Abbas, M.; Buntinx, M.; Deferme, W.; Peeters, R. (Bio)polymer/ZnO nanocomposites for packaging applications: A Review of gas barrier and mechanical properties. Nanomaterials 2019, 9, 1494. [Google Scholar] [CrossRef] [PubMed]
- Nguyen, V.T.; Vu, V.T.; Nguyen, T.H.; Nguyen, T.A.; Tran, V.K.; Nguyen-Tri, P. Antibacterial activity of TiO2- and ZnO-decorated with silver nanoparticles. J. Compos. Sci. 2019, 3, 61. [Google Scholar] [CrossRef]
- Hari, K.D.; Garcia, C.V.; Shin, G.-H.; Kim, J.-T. Improvement of the UV barrier and antibacterial properties of crosslinked pectin/zinc Oxide bionanocomposite films. Polymers 2021, 13, 2403. [Google Scholar] [CrossRef] [PubMed]
- Chong, W.J.; Shen, S.; Li, Y.; Trinchi, A.; Simunec, D.P.; Kyratzis, I.; Sola, A.; Wen, C. Biodegradable PLA-ZnO nanocomposite biomaterials with antibacterial properties, tissue engineering viability, and enhanced biocompatibility. Smart Mater. Manuf. 2023, 1, 100004. [Google Scholar] [CrossRef]
- Garcia, C.V.; Shin, G.H.; Kim, J.T. Metal oxide-based nanocomposites in food packaging: Applications, migration, and regulations. Trends Food Sci. Technol. 2018, 82, 21–31. [Google Scholar] [CrossRef]
- Dai, S.-H.; Zhang, J.-P.; Weng, L.; Li, B.-Y.; Yang, X.-H. Synthesis and properties of ZnO on nonwoven PET fiber. Chem. Phys. 2021, 551, 111335. [Google Scholar] [CrossRef]
- Ahmed, J.; Arfat, Y.A.; Al-Attar, H.; Auras, R.; Ejaz, M. Rheological, structural, ultraviolet protection and oxygen barrier properties of linear low-density polyethylene films reinforced with zinc oxide (ZnO) nanoparticles. Food Packag. Shelf. 2017, 13, 20–26. [Google Scholar] [CrossRef]
- Ding, N.; Sun, Y.; Chen, B.; Wang, D.; Tao, S.; Zhao, B.; Yunxing Li, Y. Facile preparation of raspberry-like PS/ZnO composite particles and their antibacterial properties. Colloids Surf. A Physicochem. Eng. Asp. 2020, 599, 124867. [Google Scholar] [CrossRef]
- Polat, S.; Fenercioglu, H.; Unal Turhan, E.; Guclu, M. Effects of nanoparticle ratio on structural, migration properties of polypropylene films and preservation quality of lemon juice. J. Food Process. Preserv. 2018, 42, e13541. [Google Scholar] [CrossRef]
- Noshirvani, N.; Ghanbarzadeh, B.; Mokarram, R.R.; Hashemi, M. Novel active packaging based on carboxymethyl cellulose-chitosan-ZnO NPs nanocomposite for increasing the shelf life of bread. Food Packag. Shelf. 2017, 11, 106–114. [Google Scholar] [CrossRef]
- Díez-Pascual, A.M.; Diez-Vicente, A.L. ZnO-reinforced poly(3-hydroxybutyrate-co-3-hydroxyvalerate) bionanocomposites with antimicrobial function for food packaging. ACS Appl. Mater. Interfaces 2014, 6, 9822–9834. [Google Scholar] [CrossRef] [PubMed]
- Venkatesan, R.; Rajeswari, N. ZnO/PBAT nanocomposite films: Investigation on the mechanical and biological activity for food packaging. Polym. Adv. Technol. 2017, 28, 20–27. [Google Scholar] [CrossRef]
- Chu, Z.; Zhao, T.; Li, L.; Fan, J.; Qin, Y. Characterization of antimicrobial poly (lactic acid)/nano-composite films with silver and zinc oxide nanoparticles. Materials 2017, 10, 659. [Google Scholar] [CrossRef] [PubMed]
- Zhang, H.; Hortal, M.; Jordá-Beneyto, M.; Rosa, E.; Lara-Lledo, M.; Lorente, I. ZnO-PLA nanocomposite coated paper for antimicrobial packaging application. LWT—Food Sci. Technol. 2017, 78, 250–257. [Google Scholar] [CrossRef]
- Akshaykranth, A.; Jayarambabu, N.; Venkatappa Rao, T.; Rakesh Kumar, R. Influence of MgO and ZnO nanofillers on morphology, structural, thermal and mechanical properties of polylactic acid films. Bull. Mater. Sci. 2022, 45, 247. [Google Scholar] [CrossRef]
- Baimark, Y.; Rungseesantivanon, W.; Prakymorama, N. Improvement in melt flow property and flexibility of poly(L-lactide)-b-poly(ethylene glycol)-b-poly(L-lactide) by chain extension reaction for potential use as flexible bioplastics. Mater. Des. 2018, 154, 73–80. [Google Scholar] [CrossRef]
- Yun, X.; Li, X.; Jin, Y.; Sun, W.; Dong, T. Fast crystallization and toughening of poly(L-lactic acid) by incorporating with poly(ethylene glycol) as a middle block chain. Polym. Sci. Ser. A 2018, 60, 141–155. [Google Scholar] [CrossRef]
- Sun, S.; Cui, Y.; Yuan, B.; Dou, M.; Wang, G.; Xu, H.; Wang, J.; Yin, W.; Wu, D.; Peng, C. Drug delivery systems based on polyethylene glycol hydrogels for enhanced bone regeneration. Front. Bioeng. Biotechnol. 2023, 11, 1117647. [Google Scholar] [CrossRef]
- Thongsomboon, W.; Srihanam, P.; Baimark, Y. Preparation of flexible poly(L-lactide)-b-poly(ethylene glycol)-b-poly(L-lactide)/talcum/thermoplastic starch ternary composites for use as heat-resistant and single-use bioplastics. Int. J. Biol. Macromol. 2023, 230, 123172. [Google Scholar] [CrossRef] [PubMed]
- Baimark, Y.; Rungseesantivanon, W.; Prakymoramas, N. Synthesis of flexible poly(L-lactide)-b-polyethylene glycol-b-poly(L-lactide) bioplastics by ring-opening polymerization in the presence of chain extender. e-Polymers 2020, 20, 423–429. [Google Scholar] [CrossRef]
- Srihanam, P.; Thongsomboon, W.; Baimark, Y. Phase Morphology, mechanical, and thermal properties of calcium carbonate-reinforced poly(L-lactide)-b-poly(ethylene glycol)-b-poly(L-lactide) bioplastics. Polymers 2023, 15, 301. [Google Scholar] [CrossRef] [PubMed]
- Pakkethati, K.; Srihanam, P.; Manphae, A.; Rungseesantivanon, W.; Prakymoramas, N.; Lan, P.N.; Baimark, Y. Improvement in crystallization, thermal, and mechanical properties of flexible poly(L-lactide)-b-poly(ethylene glycol)-b-poly(L-lactide) bioplastic with zinc phenylphosphate. Polymers 2024, 16, 975. [Google Scholar] [CrossRef]
- Hasheminya, S.-M.; Mokarram, R.R.; Ghanbarzadeh, B.; Hamishekar, H.; Kafil, H.S.; Dehghannya, J. Development and char-acterization of biocomposite films made from kefiran, carboxymethyl cellulose and Satureja Khuzestanica essential oil. Food Chem. 2019, 289, 443–452. [Google Scholar] [CrossRef]
- Tang, Z.; Fan, F.; Chu, Z.; Fan, C.; Qin, Y. Barrier properties and characterizations of poly(lactic acid)/ZnO nanocomposites. Molecules 2020, 25, 1310. [Google Scholar] [CrossRef] [PubMed]
- Srisuwan, Y.; Baimark, Y. Thermal, morphological and mechanical properties of flexible poly(L-lactide)-b-polyethylene glycol-b-poly(L-lactide)/thermoplastic starch blends. Carbohydr. Polym. 2022, 283, 119155. [Google Scholar] [CrossRef]
- Saeidlou, S.; Huneault, M.A.; Li, H.; Park, C.B. Poly(lactic acid) crystallization. Prog. Polym. Sci. 2012, 37, 1657–1677. [Google Scholar] [CrossRef]
- Wang, L.; Wang, Y.N.; Huang, Z.G.; Weng, Y.X. Heat resistance, crystallization behavior, and mechanical properties of polylactide/nucleating agent composites. Mater. Des. 2015, 66, 7–15. [Google Scholar] [CrossRef]
- Chen, P.; Yu, K.; Wang, Y.; Wang, W.; Zhou, H.; Li, H.; Mi, J.; Wang, X. The effect of composite nucleating agent on the crystallization behavior of branched poly(lactic acid). J. Polym. Environ. 2018, 26, 3718–3730. [Google Scholar] [CrossRef]
- Li, L.; Cao, Z.Q.; Bao, R.Y.; Xie, B.H.; Yang, M.B.; Yang, W. Poly(L-lactic acid)-polyethylene glycol-poly(L-lactic acid) triblock copolymer: A novel macromolecular plasticizer to enhance the crystallization of poly(L-lactic acid). Eur. Polym. J. 2017, 97, 272–281. [Google Scholar] [CrossRef]
- Wang, A.; Quan, W.; Zhang, H.; Li, H.; Yang, S. Heterogeneous ZnO-containing catalysts for efficient biodiesel production. RSC Adv. 2021, 11, 20465–20478. [Google Scholar] [CrossRef] [PubMed]
- Puglisi, R.; Scamporrino, A.A.; Dintcheva, N.T.; Filippone, G.; Bruno, E.; Scarfato, P.; Cerruti, P.; Carroccio, S.C. Photo- and water-degradation phenomena of ZnO bio-blend based on poly(lactic acid) and polyamide 11. Polymers 2023, 15, 1434. [Google Scholar] [CrossRef] [PubMed]
- Bindhua, B.; Renishaa, R.; Robertsb, L.; Varghese, T.O. Boron Nitride reinforced polylactic acid composites film for packaging: Preparation and properties. Polym. Test. 2018, 66, 172–177. [Google Scholar] [CrossRef]
- Kong, D.; Zhang, D.; Guo, H.; Zhao, J.; Wang, Z.; Hu, H.; Xu, J.; Fu, C. Functionalized boron nitride nanosheets/poly(L-lactide) nanocomposites and their crystallization behavior. Polymers 2019, 11, 440. [Google Scholar] [CrossRef] [PubMed]
- Mohapatra, A.K.; Mohanty, S.; Nayak, S.K. Dynamic mechanical and thermal properties of polylactide-layered silicate nanocomposites. J. Thermoplast. Compos. Mater. 2014, 27, 699–716. [Google Scholar] [CrossRef]
- Panicker, A.M.; Rajesh, K.A.; Varghese, T.O. Mixed morphology nanocrystalline cellulose from sugarcane bagasse fibers/poly(lactic acid) nanocomposite films: Synthesis, fabrication and characterization. Iran. Polym. J. 2017, 26, 125–136. [Google Scholar] [CrossRef]
- Díez-Pascual, A.M.; Díez-Vicente, A.L. Poly(3-hydroxybutyrate)/ZnO bionanocomposites with improved mechanical, barrier and antibacterial properties. Int. J. Mol. Sci. 2014, 15, 10950–10973. [Google Scholar] [CrossRef] [PubMed]
- Shankar, S.; Teng, X.; Li, G.; Rhim, J.W. Preparation, characterization, and antimicrobial activity of gelatin/ZnO nanocomposite films. Food Hydrocoll. 2015, 45, 264–271. [Google Scholar] [CrossRef]
- Ngo, T.M.P.; Dang, T.M.Q.; Tran, T.X.; Rachtanapun, P. Effects of zinc oxide nanoparticles on the properties of pectin/alginate edible films. Int. J. Polym. Sci. 2018, 2018, 5645797. [Google Scholar] [CrossRef]
- Mizielinska, M.; Kowalska, U.; Jarosz, M.; Suminska, P.; Landercy, N.; Duquesne, E. The effect of UV aging on antimicrobial and mechanical properties of PLA films with incorporated zinc oxide nanoparticles. Int. J. Environ. Res. Public Health 2018, 15, 794. [Google Scholar] [CrossRef]
- Haque, M.; Sartelli, M.; McKimm, J.; Abu Bakar, M. Health care-associated infections—An overview. Infect. Drug Resist. 2018, 11, 2321–2333. [Google Scholar] [CrossRef]
- Toh-ae, P.; Lee-Nip, R.; Nakaramontri, Y. Releasing of zinc ions from modified zinc oxide surfaces for improvement chemical crosslinks and antibacterial properties of acrylonitrile butadiene rubber films. Express Polym. Lett. 2023, 17, 944–963. [Google Scholar] [CrossRef]

| Nano-ZnO Content (wt%) | Tg (°C) | Tcc (°C) | ΔHcc (J/g) | Tm (°C) | ΔHm (J/g) | DSC-Xc (%) |
|---|---|---|---|---|---|---|
| - | 32 | 81 | 20.9 | 159 | 31.3 | 13.4 |
| 1 | 31 | 64 | 9.6 | 160 | 31.1 | 27.9 |
| 2 | 31 | - | - | 160 | 30.8 | 40.4 |
| 3 | 32 | 64 | 8.4 | 160 | 30.9 | 29.9 |
| 4 | 29 | 68 | 16.3 | 157 | 31.2 | 20.0 |
| Nano-ZnO Content (wt%) | Tc (°C) | ΔHc (J/g) |
|---|---|---|
| - | 99 | 10.5 |
| 1 | 108 | 31.2 |
| 2 | 110 | 32.2 |
| 3 | 99 | 29.5 |
| 4 | 83 | 8.5 |
| Nano-ZnO Content (wt%) | 5%-Td 1 (°C) | Residue Weight at 800 °C 1 (%) | PLLA-Td,max 2 (°C) | PEG-Td,max 2 (°C) |
|---|---|---|---|---|
| - | 282 | 0.4 | 310 | 416 |
| 1 | 269 | 1.3 | 308 | 415 |
| 2 | 266 | 2.2 | 304 | 415 |
| 3 | 264 | 3.5 | 300 | 413 |
| 4 | 261 | 4.5 | 296 | 413 |
| Nano-ZnO Content (wt%) | Stress at Yield (MPa) | Stress at Break (MPa) | Strain at Break (%) | Young’s Modulus (MPa) | Opacity (mm−1) |
|---|---|---|---|---|---|
| - | 21.2 ± 2.5 | 17.4 ± 3.3 | 102 ± 8 | 312 ± 27 | 0.29 ± 0.02 |
| 1 | 27.6 ± 3.1 | 18.2 ± 4.8 | 57 ± 6 | 396 ± 25 | 1.19 ± 0.05 |
| 2 | 29.4 ± 2.2 | 21.3 ± 4.1 | 41 ± 4 | 406 ± 34 | 1.56 ± 0.04 |
| 3 | 17.8 ± 3.6 | 14.7 ± 4.7 | 29 ± 6 | 274 ± 18 | 1.64 ± 0.09 |
| 4 | - * | - * | - * | - * | 2.10 ± 0.12 |
| Nano-ZnO Content (wt%) | Inhibition Zone (mm) | |
|---|---|---|
| E. coli TISTR 780 | S. aureus TISTR 1466 | |
| 0 | 0 | 0 |
| 1 | 12.3 ± 0.6 | 12.7 ± 0.6 |
| 2 | 15.3 ± 0.6 | 18.7 ± 0.6 |
| 3 | 15.7 ± 0.7 | 19.3 ± 0.5 |
| 4 | 16.0 ± 0.1 | 22.3 ± 0.6 |
Disclaimer/Publisher’s Note: The statements, opinions and data contained in all publications are solely those of the individual author(s) and contributor(s) and not of MDPI and/or the editor(s). MDPI and/or the editor(s) disclaim responsibility for any injury to people or property resulting from any ideas, methods, instructions or products referred to in the content. |
© 2024 by the authors. Licensee MDPI, Basel, Switzerland. This article is an open access article distributed under the terms and conditions of the Creative Commons Attribution (CC BY) license (https://creativecommons.org/licenses/by/4.0/).
Share and Cite
Srisuwan, Y.; Srihanam, P.; Rattanasuk, S.; Baimark, Y. Preparation of Poly(L-lactide)-b-poly(ethylene glycol)-b-poly(L-lactide)/Zinc Oxide Nanocomposite Bioplastics for Potential Use as Flexible and Antibacterial Food Packaging. Polymers 2024, 16, 1660. https://doi.org/10.3390/polym16121660
Srisuwan Y, Srihanam P, Rattanasuk S, Baimark Y. Preparation of Poly(L-lactide)-b-poly(ethylene glycol)-b-poly(L-lactide)/Zinc Oxide Nanocomposite Bioplastics for Potential Use as Flexible and Antibacterial Food Packaging. Polymers. 2024; 16(12):1660. https://doi.org/10.3390/polym16121660
Chicago/Turabian StyleSrisuwan, Yaowalak, Prasong Srihanam, Surachai Rattanasuk, and Yodthong Baimark. 2024. "Preparation of Poly(L-lactide)-b-poly(ethylene glycol)-b-poly(L-lactide)/Zinc Oxide Nanocomposite Bioplastics for Potential Use as Flexible and Antibacterial Food Packaging" Polymers 16, no. 12: 1660. https://doi.org/10.3390/polym16121660
APA StyleSrisuwan, Y., Srihanam, P., Rattanasuk, S., & Baimark, Y. (2024). Preparation of Poly(L-lactide)-b-poly(ethylene glycol)-b-poly(L-lactide)/Zinc Oxide Nanocomposite Bioplastics for Potential Use as Flexible and Antibacterial Food Packaging. Polymers, 16(12), 1660. https://doi.org/10.3390/polym16121660

